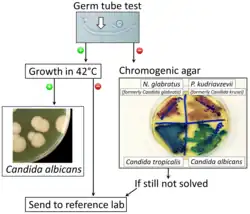

Candida albicans
| Candida albicans | |
|---|---|
 | |
| Candida albicans visualized using scanning electron microscopy. Note the abundant hyphal mass. | |
| Scientific classification | |
| Kingdom: | Fungi |
| Division: | Ascomycota |
| Class: | Pichiomycetes |
| Order: | Serinales |
| Family: | Debaryomycetaceae |
| Genus: | Candida |
| Species: | C. albicans |
| Binomial name | |
| Candida albicans (C.-P. Robin) Berkhout (1923) | |
| Synonyms | |
Candida albicans is an opportunistic pathogenic yeast[5] that is a common member of the human gut flora. It can also survive outside the human body.[6][7] It is detected in the gastrointestinal tract and mouth in 40–60% of healthy adults.[8][9] It is usually a commensal organism, but it can become pathogenic in immunocompromised individuals under a variety of conditions.[9][10] It is one of the few species of the genus Candida that cause the human infection candidiasis, which results from an overgrowth of the fungus.[9][10] Candidiasis is, for example, often observed in HIV-infected patients.[11] C. albicans is the most common fungal species isolated from biofilms either formed on (permanent) implanted medical devices or on human tissue.[12][13] C. albicans, C. tropicalis, C. parapsilosis, and C. glabrata are together responsible for 50–90% of all cases of candidiasis in humans.[10][14][15] A mortality rate of 40% has been reported for patients with systemic candidiasis due to C. albicans.[16] By one estimate, invasive candidiasis contracted in a hospital causes 2,800 to 11,200 deaths yearly in the US.[14] Nevertheless, these numbers may not truly reflect the true extent of damage this organism causes, given studies indicating that C. albicans can cross the blood–brain barrier in mice.[17][18]
C. albicans is commonly used as a model organism for fungal pathogens.[19] It is generally referred to as a dimorphic fungus since it grows both as yeast and filamentous cells. However, it has several different morphological phenotypes including opaque, GUT, and pseudohyphal forms.[20][21] C. albicans was for a long time considered an obligate diploid organism without a haploid stage. This is, however, not the case. Next to a haploid stage C. albicans can also exist in a tetraploid stage. The latter is formed when diploid C. albicans cells mate when they are in the opaque form.[22] The diploid genome size is approximately 29 Mb, and up to 70% of the protein coding genes have not yet been characterized.[23] C. albicans is easily cultured in the lab and can be studied both in vivo and in vitro. Depending on the media different studies can be done as the media influences the morphological state of C. albicans. A special type of medium is CHROMagar Candida, which can be used to identify different Candida species.[24][25]
Etymology
"Candida albicans" can be read as tautological. "Candida" comes from the Latin word "candidus", meaning "shining white". "Albicans" itself is the present participle of the Latin word "albicō", meaning "becoming white". This leads to one possible interpretation as the redundant phrase "pure white becoming white".
It is often shortly referred to as thrush, candidiasis, or candida. More than a hundred synonyms have been used to describe C. albicans.[2][26] Over 200 species have been described within the candida genus. The oldest reference to thrush, most likely caused by C. albicans, dates back to 400 BC in Hippocrates' work Of the Epidemics describing oral candidiasis.[2][27]
Genome


The genome of C. albicans is almost 16Mb for the haploid size (28Mb for the diploid stage) and consists of 8 sets of chromosome pairs called chr1A, chr2A, chr3A, chr4A, chr5A, chr6A, chr7A and chrRA. The second set (C. albicans is diploid) has similar names but with a B at the end. Chr1B, chr2B, ... and chrRB. The whole genome contains 6,198 open reading frames (ORFs). Seventy percent of these ORFs have not yet been characterized. The whole genome has been sequenced making it one of the first fungi to be completely sequenced (next to Saccharomyces cerevisiae and Schizosaccharomyces pombe).[11][23] All open reading frames (ORFs) are also available in Gateway-adapted vectors. Next to this ORFeome there is also the availability of a GRACE (gene replacement and conditional expression) library to study essential genes in the genome of C. albicans.[28][29] The most commonly used strains to study C. albicans are the WO-1 and SC5314 strains. The WO-1 strain is known to switch between white-opaque form with higher frequency while the SC5314 strain is the strain used for gene sequence reference.[30]
One of the most important features of the C. albicans genome is the high heterozygosity. At the base of this heterozygosity lies the occurrence of numeric and structural chromosomal rearrangements and changes as means of generating genetic diversity by chromosome length polymorphisms (contraction/expansion of repeats), reciprocal translocations, chromosome deletions, Nonsynonymous single-nucleotide polymorphisms and trisomy of individual chromosomes. These karyotypic alterations lead to changes in the phenotype, which is an adaptation strategy of this fungus. These mechanisms are further being explored with the availability of the complete analysis of the C. albicans genome.[31][32][33]
An unusual feature of the genus Candida is that in many of its species (including C. albicans and C. tropicalis, but not, for instance, C. glabrata) the CUG codon, which normally specifies leucine, specifies serine in these species. This is an unusual example of a departure from the standard genetic code, and most such departures are in start codons or, for eukaryotes, mitochondrial genetic codes.[34][35][36] This alteration may, in some environments, help these Candida species by inducing a permanent stress response, a more generalized form of the heat shock response.[37] However, this different codon usage makes it more difficult to study C. albicans protein-protein interactions in the model organism S. cerevisiae. To overcome this problem a C. albicans specific two-hybrid system was developed.[38]
The genome of C. albicans is highly dynamic, contributed by the different CUG translation, and this variability has been used advantageously for molecular epidemiological studies and population studies in this species. The genome sequence has allowed for identifying the presence of a parasexual cycle (no detected meiotic division) in C. albicans.[39] This study of the evolution of sexual reproduction in six Candida species found recent losses in components of the major meiotic crossover-formation pathway, but retention of a minor pathway.[39] The authors suggested that if Candida species undergo meiosis it is with reduced machinery, or different machinery, and indicated that unrecognized meiotic cycles may exist in many species. In another evolutionary study, introduction of partial CUG identity redefinition (from Candida species) into Saccharomyces cerevisiae clones caused a stress response that negatively affected sexual reproduction. This CUG identity redefinition, occurring in ancestors of Candida species, was thought to lock these species into a diploid or polyploid state with possible blockage of sexual reproduction.[40]
Morphology
C. albicans exhibits a wide range of morphological phenotypes due to phenotypic switching and bud to hypha transition. The yeast-to-hyphae transition (filamentation) is a rapid process and induced by environmental factors. Phenotypic switching is spontaneous, happens at lower rates and in certain strains up to seven different phenotypes are known. The best studied switching mechanism is the white to opaque switching (an epigenetic process). Other systems have been described as well. Two systems (the high-frequency switching system and white to opaque switching) were discover by David R. Soll and colleagues.[41][42] Switching in C. albicans is often, but not always, influenced by environmental conditions such as the level of CO2, anaerobic conditions, medium used and temperature.[43] In its yeast form C. albicans ranges from 10 to 12 microns.[44] Spores can form on the pseudohyphae called chlamydospores which survive when put in unfavorable conditions such as dry or hot seasons.[45]

Yeast-to-hypha switching
Although often referred to as dimorphic, C. albicans is, in fact, polyphenic (often also referred to as pleomorphic).[46] When cultured in standard yeast laboratory medium, C. albicans grows as ovoid "yeast" cells. However, mild environmental changes in temperature, CO2, nutrients and pH can result in a morphological shift to filamentous growth.[47][48] Filamentous cells share many similarities with yeast cells. Both cell types seem to play a specific, distinctive role in the survival and pathogenicity of C. albicans. Yeast cells seem to be better suited for the dissemination in the bloodstream while hyphal cells have been proposed as a virulence factor. Hyphal cells are invasive and speculated to be important for tissue penetration, colonization of organs and surviving plus escaping macrophages.[49][50][51] The transition from yeast to hyphal cells is termed to be one of the key factors in the virulence of C. albicans; however, it is not deemed necessary.[52] When C. albicans cells are grown in a medium that mimics the physiological environment of a human host, they grow as filamentous cells (both true hyphae and pseudohyphae). C. albicans can also form chlamydospores, the function of which remains unknown, but it is speculated they play a role in surviving harsh environments as they are most often formed under unfavorable conditions.[53]
The cAMP-PKA signaling cascade is crucial for the morphogenesis and an important transcriptional regulator for the switch from yeast like cells to filamentous cells is EFG1.[54][55]


High-frequency switching
Besides the well-studied yeast-to-hyphae transition other switching systems have been described.[56] One such system is the "high-frequency switching" system. During this switching different cellular morphologies (phenotypes) are generated spontaneously. This type of switching does not occur en masse, represents a variability system and it happens independently from environmental conditions.[43] The strain 3153A produces at least seven different colony morphologies.[57][42][58] In many strains the different phases convert spontaneously to the other(s) at a low frequency. The switching is reversible, and colony type can be inherited from one generation to another. Being able to switch through so many different (morphological) phenotypes makes C. albicans able to grow in different environments, both as a commensal and as a pathogen.[59]
In the 3153A strain, a gene called SIR2 (for silent information regulator), which seems to be important for phenotypic switching, has been found.[60][61] SIR2 was originally found in Saccharomyces cerevisiae (brewer's yeast), where it is involved in chromosomal silencing—a form of transcriptional regulation, in which regions of the genome are reversibly inactivated by changes in chromatin structure (chromatin is the complex of DNA and proteins that make chromosomes). In yeast, genes involved in the control of mating type are found in these silent regions, and SIR2 represses their expression by maintaining a silent-competent chromatin structure in this region.[62] The discovery of a C. albicans SIR2 implicated in phenotypic switching suggests it, too, has silent regions controlled by SIR2, in which the phenotype-specific genes may reside. How SIR2 itself is regulated in S. cerevisiae may yet provide more clues as to the switching mechanisms of C. albicans.
White-opaque switching
Next to the dimorphism and the first described high-frequency switching system C. albicans undergoes another high-frequency switching process called white-opaque switching, which is another phenotypic switching process in C. albicans. It was the second high-frequency switching system discovered in C. albicans.[41] The white-opaque switch is an epigenetic switching system.[63] Phenotypic switching is often used to refer to white-opaque switching, which consists of two phases: one that grows as round cells in smooth, white colonies (referred to as white form) and one that is rod-like and grows as flat, gray colonies (called opaque form). This switch between white cells and opaque cells is important for the virulence and the mating process of C. albicans as the opaque form is the mating competent form, being a million times more efficient in mating compared to the white type.[63][64][65] This switching between white and opaque form is regulated by the WOR1 regulator (White to Opaque Regulator 1) which is controlled by the mating type locus (MTL) repressor (a1-α2) that inhibits the expression of WOR1.[66] Besides the white and opaque phase there is also a third one: the gray phenotype. This phenotype shows the highest ability to cause cutaneous infections. The white, opaque, and gray phenotypes form a phenotypic switching system where white cells switch to and from the opaque phase, white cells can irreversibly switch to the gray phase, and both white and gray cells can switch to and from the opaque/an opaque-like phase, respectively.[59][67] Since it is often difficult to differentiate between white, opaque and gray cells phloxine B, a dye, can be added to the medium.[59]
A potential regulatory molecule in the white to opaque switching is Efg1p, a transcription factor found in the WO-1 strain that regulates dimorphism, and more recently has been suggested to help regulate phenotypic switching. Efg1p is expressed only in the white and not in the gray cell-type, and overexpression of Efg1p in the gray form causes a rapid conversion to the white form.[68][69][67]
Environmental stress
Glucose starvation is a likely common environmental stress encountered by C. albicans in its natural habitat.[70] Glucose starvation causes an increase in intracellular reactive oxygen. This stress can lead to mating between two individuals of the same mating type, an interaction that may be frequent in nature under stressful conditions.[70]
White-GUT switch
A very special type of phenotypic switch is the white-GUT switch (Gastrointestinally-IndUced Transition). GUT cells are extremely adapted to survival in the digestive tract by metabolic adaptations to available nutrients in the digestive tract. The GUT cells live as commensal organisms and outcompete other phenotypes. The transition from white to GUT cells is driven by passage through the gut where environmental parameters trigger this transition by increasing the WOR1 expression.[71][72]
Role in disease
Candida is found worldwide but most commonly compromises immunocompromised individuals diagnosed with serious diseases such as HIV and cancer. Candida are ranked as one of the most common groups of organisms that cause hospital-acquired infections. Especially high-risk individuals are patients that have recently undergone surgery, a transplant or are in the Intensive Care Units (ICU),[73] C. albicans infections is the top source of fungal infections in critically ill or otherwise immunocompromised patients.[74] These patients predominantly develop oropharyngeal or thrush candidiasis, which can lead to malnutrition and interfere with the absorption of medication.[75] Methods of transmission include mother to infant through childbirth, people-to-people acquired infections that most commonly occur in hospital settings where immunocompromised patients acquire the yeast from healthcare workers and has a 40% incident rate. People can become infected after having sex with a woman that has an existing vaginal yeast infection.[73] Parts of the body that are commonly infected include the skin, genitals, throat, mouth, and blood.[76] Distinguishing features of vaginal infection include discharge, and dry and red appearance of vaginal mucosa or skin. Candida continues to be the fourth most commonly isolated organism in bloodstream infections.[77] Healthy people usually do not suffer (severely) from superficial infections caused by a local alteration in cellular immunity as seen by asthma patients that use oral corticosteroids.
Superficial and local infections
It commonly occurs as a superficial infection on mucous membranes in the mouth or vagina. Once in their lives around 75% of women will suffer from vulvovaginal candidiasis (VVC) and about 90% of these infections are caused by C. albicans. It may also affect a number of other regions. For example, higher prevalence of colonization of C. albicans was reported in young individuals with tongue piercing, in comparison to unpierced matched individuals,[78] but not in healthy young individuals who use intraoral orthodontic acrylic appliances.[79] To infect host tissue, the usual unicellular yeast-like form of C. albicans reacts to environmental cues and switches into an invasive, multicellular filamentous form, a phenomenon called dimorphism.[80] In addition, an overgrowth infection is considered a superinfection, the term usually applied when an infection becomes opportunistic and very resistant to antifungals. It then becomes suppressible by antibiotics. The infection is prolonged when the original sensitive strain is replaced by the antifungal-resistant strain.[81]
Candidiasis is known to cause gastrointestinal (GI) symptoms particularly in immunocompromised patients or those receiving steroids (e.g. to treat asthma) or antibiotics. Recently, there is an emerging literature that an overgrowth of fungus in the small intestine of non-immunocompromised subjects may cause unexplained GI symptoms. Small intestinal fungal overgrowth (SIFO) is characterized by the presence of an excessive number of fungal organisms in the small intestine associated with gastrointestinal symptoms. The most common symptoms observed in these patients were belching, bloating, indigestion, nausea, diarrhea, and gas. The underlying mechanism(s) that predisposes to SIFO is unclear. Further studies are needed; both to confirm these observations and to examine the clinical relevance of fungal overgrowth.[9][10][82]
Systemic infections
Systemic fungal infections (fungemias) including those by C. albicans have emerged as important causes of morbidity and mortality in immunocompromised patients (e.g., AIDS, cancer chemotherapy, organ or bone marrow transplantation). C. albicans often forms biofilms inside the body. Such C. albicans biofilms may form on the surface of implantable medical devices or organs. In these biofilms it is often found together with Staphylococcus aureus.[12][13][83][84] Such multispecies infections lead to higher mortalities.[85] In addition hospital-acquired infections by C. albicans have become a cause of major health concerns.[11][86] Especially once candida cells are introduced in the bloodstream a high mortality, up to 40–60% can occur.[11][87]
Although Candida albicans is the most common cause of candidemia, there has been a decrease in the incidence and an increased isolation of non-albicans species of Candida in recent years.[88] Preventive measures include maintaining a good oral hygiene, keeping a healthy lifestyle including good nutrition, the careful use of antibiotics, treatment of infected areas and keeping skin dry and clean, free from open wounds.[89][90]
Role of C. albicans in Crohn's disease
The link between C. albicans and Crohn's disease has been investigated in a large cohort. This study demonstrated that members of families with multiple cases of Crohn's disease were more likely to be colonized by C. albicans than members of control families.[91] Experimental studies show that chemically induced colitis promotes C. albicans colonization. In turn, C. albicans colonization generates anti-Saccharomyces cerevisiae antibodies (ASCA), increases inflammation, histological scores and pro-inflammatory cytokine expression.[92][93]
Diagnosis
A United States study in 2022 showed that most cases of candidiasis are treated empirically (without culture, pending culture or by symptoms in cases where culture did not show candida), thus not knowing whether the subtype is Candida albicans or any other candida species.[94] For subtyping of candidiasis, a fungal culture can be performed, followed by a germ tube test in which a sample of fungal spores are suspended in animal serum and examined by microscopy for the detection of any germ tubes.[95] Colonies of white or cream color on fungal culture having a positive germ tube test is strongly indicative of Candida albicans.[95]
-
 Agar plate culture of C. albicans
Agar plate culture of C. albicans -
 Germ tubes of Candida albicans
Germ tubes of Candida albicans -
 Gram stain of Candida albicans from a vaginal swab; the small oval chlamydospores are 2–4 μm in diameter
Gram stain of Candida albicans from a vaginal swab; the small oval chlamydospores are 2–4 μm in diameter -
 Chromogenic agar can help in indicating main species of Candida versus similar fungi. (CHROMAgar shown)
Chromogenic agar can help in indicating main species of Candida versus similar fungi. (CHROMAgar shown) -
Algorithm for the diagnosis of Candida albicans versus differential diagnoses
Algorithm for the diagnosis of Candida albicans versus differential diagnoses
Treatment
There are relatively few drugs that can successfully treat Candidiasis.[96][97] Treatment commonly includes:[98]
- amphotericin B, echinocandin, or fluconazole for systemic infections
- nystatin for oral and esophageal infections
- clotrimazole for skin and genital yeast infections[99]
Similarly to antibiotic resistance, resistance to many anti-fungals is becoming a problem. New anti-fungals have to be developed to cope with this problem since only a limited number of anti-fungals are available.[96][100] A general problem is that in contrast to bacteria, fungi are often overlooked as a potential health problem.[101]
One study demonstrated that the fungal commensal Kazachstania weizmannii can suppress C. albicans.[102]
Economic implications
Given the fact that candidiasis is the fourth- (to third-) most frequent hospital acquired infection worldwide it leads to immense financial implications. Approximately 60,000 cases of systemic candidiasis each year in the USA alone lead up to a cost to be between $2–4 billion.[103] The total costs for candidiasis are among the highest compared to other fungal infections due to the high prevalence.[104] The immense costs are partly explained by a longer stay in the intensive care unit or hospital in general. An extended stay for up to 21 more days compared to non-infected patients is not uncommon.[105]
Role of GSDMD in C. albicans infection
Gasdermin D (GSDMD) is a protein that in humans is encoded by the GSDMD gene and is a known target of the inflammasome and acts as an effector molecule of programmed cell death known as pyroptosis. This protein determines cell lysis to prevent pathogen replication and results in the release of the inflammatory cytokine interleukin-1β (IL-1β) into the extracellular space to recruit and activate immune cells at the site of infection. Inflammasome activation due to C.albicans infection triggers the release of a cytokine storm necessary to fight the pathogen. Excessive release of these pro-inflammatory mediators has been shown to exaggerate systemic inflammation leading to vascular injury and damage to vital organs. Unfortunately, Candida albicans therapy is often ineffective despite the availability of many antifungal drugs, mainly because of resistance phenomena. During conventional pyroptosis controlled by the inflammasome-GSDMD axis is hijacked by C. albicans to facilitate escape from macrophages through unfolding of hyphae and candidalysin, a fungal toxin released from hyphae. It has been shown[106] that disruption of GSDMD in macrophages infected with Candida albicans reduces the fungal load. In addition, the presence of hyphae and candidalysin are key factors in the activation of GSDMD and the release of Candida from macrophages. Also using Candida-infected mice, inhibition of GSDMD has been shown to paradoxically improve prognosis and survival, indicating that this protein may be a potential therapeutic target in C. albicans-induced sepsis.
Biofilm development
Biofilm formation steps
The biofilm of C. albicans is formed in four steps. First, there is the initial adherence step, where the yeast-form cells adhere to the substrate. The second step is called Intermediate step, where the cells propagate to form micro colonies, and germ tubes form to yield hyphae. In the maturation step, the biofilm biomass expands, the extracellular matrix accumulates and drug resistance increases. In the last step of biofilm formation, the yeast-form cells are released to colonize the surrounding environment (dispersion). Yeast cells released from a biofilm have novel properties, including increased virulence and drug tolerance.[107][108][109]
Zap1
Zap1, also known as Csr1 and Sur1 (zinc-responsive activator protein), is a transcription factor required for the C. albicans hypha formation in biofilms. Zap1 controls the equilibrium of yeast and hyphal cells, the zinc transporters and zinc regulated genes in biofilms of C. albicans.[110]
Zinc
Zinc (Zn2+) is important for cell function of C. albicans and Zap1 controls the Zinc levels in the cells through the zinc transporters Zrt1 and Zrt2. The regulation of zinc concentration in the cells is important for the cell viability and if the zinc levels get too high, it is toxic for the cells. The Zrt1 is transporting the zinc ions with high affinity and the Zrt2 is transporting the zinc ions with low affinity.[111]
Mechanisms and proteins important for pathogenesis
Filamentation
The ability to switch between yeast cells and hyphal cells is an important virulence factor. Many proteins play a role in this very complex process.[112] The formation of hyphae can for example help Candida albicans to escape from macrophages in the human body.[113] Moreover, C. albicans undergo yeast-to-hyphal transition within the acidic macrophage phagosome. This initially causes phagosome membrane distension which eventually leads to phagosomal alkalinization by physical rupture, followed by escape.[114]
Hwp1
Hwp1 stands for Hyphal wall protein 1. Hwp1 is a mannoprotein located on the surface of the hyphae in the hyphal form of C. albicans. Hwp1 is a mammalian transglutaminase substrate. This host enzyme allows Candida albicans to attach stably to host epithelial cells.[115] Adhesion of C. albicans to host cells is an essential first step in the infection process for colonization and subsequent induction of mucosal infection.
Slr1
The RNA-binding protein Slr1 plays a role in instigating hyphal formation and virulence in C. albicans.[116]
Candidalysin
Candidalysin is a cytolytic 31-amino acid α-helical peptide toxin that is released by C. albicans during hyphal formation. It contributes to virulence during mucosal infections.[117]
PRA1
During vaginal infections PRA1 (pH-regulated antigen) gene is up-regulated. Its expression correlates with the concentration of proinflammatory cytokines.[118]
Genetic and genomic tools
Due to its nature as a model organism, being an important human pathogen and the alternative codon usage (CUG translated into serine rather than leucine), several specific projects and tools have been created to study C. albicans.[11] The diploid nature and the absence of a sexual cycle make the organism difficult to study, but in the last 20 years, many systems have been developed to observe its genetics.[19]
Selection markers
The selection markers most used in C. albicans are the CaNAT1 resistance marker (confers resistance against nourseothricin) and MPAr or IMH3r (confers resistance to mycophenolic acid).[119] Next to the above-mentioned selection makers a few auxotrophic strains were generated to work with auxotrophic makers. The URA3 marker (URA3 blaster method) is an often-used strategy in uridine auxotrophic strains; however, studies have shown that differences in URA3 position in the genome can be involved in the pathogeny of C. albicans.[120] Besides the URA3 selection one can also use the histidine, leucine and arginine autotrophy. The advantage of using those autotrophies lies in the fact that they exhibit wild-type or nearly wild-type virulence in a mouse model compared to the URA3 system.[121] One application of the leucine, arginine and histidine autotrophy is for example the candida two-hybrid system.[38]
Full sequence genome
The full genome of C. albicans has been sequenced and made publicly available in a Candida database. The heterozygous diploid strain used for this full genome sequence project is the laboratory strain SC5314. The sequencing was done using a whole-genome shotgun approach.[122]
ORFeome project
Every predicted ORF has been created in a gateway adapted vector (pDONR207) and made publicly available. The vectors (plasmids) can be propagated in E.coli and grown on LB+gentamicin medium. This way every ORF is readily available in an easy to use vector. Using the gateway system it is possible to transfer the ORF of interest to any other gateway adapted vector for further studies of the specific ORF.[29][123]
CIp10 integrative plasmid
Contrary to the yeast S. cerevisiae episomal plasmids do not stay stable in C. albicans. In order to work with plasmids in C. albicans an integrative approach (plasmid integration into the genome) thus has to be used. A second problem is that most plasmid transformations are rather inefficient in C. albicans; however, the CIp10 plasmid overcomes these problems and can be used with ease to transform C. albicans in a very efficient way. The plasmid integrates inside the RP10 locus as disruption of one RP10 allele does not seem to affect the viability and growth of C. albicans. Several adaptations of this plasmid have been made after the original became available.[124][125]
Candida two-hybrid (C2H) system
Due to the aberrant codon usage of C. albicans it is less feasible to use the common host organism (Saccharomyces cerevisiae) for two-hybrid studies. To overcome this problem a C. albicans two-hybrid (C2H) system was created. The strain SN152 that is auxotrophic for leucine, arginine and histidine was used to create this C2H system. It was adapted by integrating a HIS1 reporter gene preceded by five LexAOp sequences. In the C2H system the bait plasmid (pC2HB) contains the Staphylococcus aureus LexA BD, while the prey plasmid (pC2HP) harbors the viral AD VP16. Both plasmids are integrative plasmids since episomal plasmids do not stay stable in C. albicans. The reporter gene used in the system is the HIS1 gene. When proteins interact, the cells will be able to grow on medium lacking histidine due to the activation of the HIS1 reporter gene.[11][38] Several interactions have thus far been detected using this system in a low scale set up.[38][126] A first high-throughput screening has also been performed.[127][128] Interacting proteins can be found at the BioGRID.[129]
Bimolecular fluorescence complementation (BiFC)
Besides the C2H system, a BiFC system has been developed to study protein-protein interactions in C. albicans. With this systems protein interactions can be studied in their native sub cellular location contrary to a C2H system in which the proteins are forced into the nucleus. With BiFC one can study for example protein interactions that take place at the cell membrane or vacuolar membrane.[128][130][131]
Microarrays
Both DNA and protein microarrays were designed to study DNA expression profiles and antibody production in patients against C. albicans cell wall proteins.[125][132]
GRACE library
Using a tetracycline-regulatable promoter system a gene replacement and conditional expression (GRACE) library was created for 1,152 genes. By using the regulatable promoter and having deleted 1 of the alleles of the specific gene it was possible to discriminate between non-essential and essential genes. Of the tested 1,152 genes 567 showed to be essential. The knowledge on essential genes can be used to discover novel antifungals.[28]
CRISPR/Cas9
CRISPR/Cas9 has been adapted to be used in C. albicans.[133] Several studies have been performed using this system.[134][135]
Application in engineering
C. albicans has been used in combination with carbon nanotubes (CNT) to produce stable electrically conductive bio-nano-composite tissue materials that have been used as temperature-sensing elements.[136]
Notable C. albicans researchers
See also
- Intestinal permeability
- Torula yeast (Candida utilis)
- Neonatal infection
- Codon usage
References
- ^ Candida albicans at NCBI Taxonomy browser Archived 2018-12-15 at the Wayback Machine, url accessed 2006-12-26
- ^ a b c Kurtzman CP, Fell JW (1998). The yeasts, a taxonomic study (4 ed.). Elsevier. ISBN 978-0444813121.
- ^ Saygin D, Tabib T, Bittar HE, Valenzi E, Sembrat J, Chan SY, et al. (May 1952). "Transcriptional profiling of lung cell populations in idiopathic pulmonary arterial hypertension". Pulmonary Circulation. 10 (1): 137–164. doi:10.2307/2394509. JSTOR 2394509. PMC 7052475. PMID 32166015.
- ^ "Synonymy of Candida albicans". speciesfungorum.org. Archived from the original on 8 December 2021. Retrieved 8 December 2021.
- ^ Gow NA, Yadav B (August 2017). "Microbe Profile: Candida albicans: a shape-changing, opportunistic pathogenic fungus of humans". Microbiology. 163 (8): 1145–1147. doi:10.1099/mic.0.000499. hdl:2164/12360. PMID 28809155.
- ^ Bensasson D, Dicks J, Ludwig JM, Bond CJ, Elliston A, Roberts IN, James SA (January 2019). "Diverse Lineages of Candida albicans Live on Old Oaks". Genetics. 211 (1): 277–288. doi:10.1534/genetics.118.301482. PMC 6325710. PMID 30463870.
- ^ Odds FC (1988). Candida and Candidosis: A Review and Bibliography (2nd ed.). London; Philadelphia: Bailliere Tindall. ISBN 978-0702012655.
- ^ Kerawala C, Newlands C, eds. (2010). Oral and maxillofacial surgery. Oxford: Oxford University Press. pp. 446, 447. ISBN 978-0-19-920483-0.
- ^ a b c d Erdogan A, Rao SS (April 2015). "Small intestinal fungal overgrowth". Current Gastroenterology Reports. 17 (4) 16. doi:10.1007/s11894-015-0436-2. PMID 25786900. S2CID 3098136.
- ^ a b c d Martins N, Ferreira IC, Barros L, Silva S, Henriques M (June 2014). "Candidiasis: predisposing factors, prevention, diagnosis and alternative treatment". Mycopathologia. 177 (5–6): 223–240. doi:10.1007/s11046-014-9749-1. hdl:10198/10147. PMID 24789109. S2CID 795450.
Candida species and other microorganisms are involved in this complicated fungal infection, but Candida albicans continues to be the most prevalent. In the past two decades, it has been observed that abnormal overgrowth in the gastrointestinal, urinary and respiratory tracts, not only in immunocompromised patients, but also related to nosocomial infections and even in healthy individuals. There is a wide variety of causal factors that contribute to yeast infection which means that candidiasis is a good example of a multifactorial syndrome.
- ^ a b c d e f Calderone A, Clancy CJ, eds. (2012). Candida and Candidiasis (2nd ed.). ASM Press. ISBN 978-1-55581-539-4.
- ^ a b Kumamoto CA (December 2002). "Candida biofilms". Current Opinion in Microbiology. 5 (6): 608–611. doi:10.1016/s1369-5274(02)00371-5. PMID 12457706.
- ^ a b Donlan RM (October 2001). "Biofilm formation: a clinically relevant microbiological process". Clinical Infectious Diseases. 33 (8): 1387–1392. doi:10.1086/322972. PMID 11565080.
- ^ a b Pfaller MA, Diekema DJ (January 2007). "Epidemiology of invasive candidiasis: a persistent public health problem". Clinical Microbiology Reviews. 20 (1): 133–163. doi:10.1128/CMR.00029-06. PMC 1797637. PMID 17223626.
- ^ Schlecht LM, Peters BM, Krom BP, Freiberg JA, Hänsch GM, Filler SG, et al. (January 2015). "Systemic Staphylococcus aureus infection mediated by Candida albicans hyphal invasion of mucosal tissue". Microbiology. 161 (Pt 1): 168–181. doi:10.1099/mic.0.083485-0. PMC 4274785. PMID 25332378.
- ^ Singh R, Chakrabarti A (2017). "Invasive Candidiasis in the Southeast-Asian Region". In Prasad R (ed.). Candida albicans: Cellular and Molecular Biology (2 ed.). Switzerland: Springer International Publishing AG. p. 27. ISBN 978-3-319-50408-7.
- ^ Wu Y, Du S, Johnson JL, Tung HY, Landers CT, Liu Y, et al. (January 2019). "Microglia and amyloid precursor protein coordinate control of transient Candida cerebritis with memory deficits". Nature Communications. 10 (1) 58. Bibcode:2019NatCo..10...58W. doi:10.1038/s41467-018-07991-4. PMC 6320369. PMID 30610193.
- ^ "Fungi cause brain infection and impair memory in mice". Archived from the original on 2023-11-20. Retrieved 2019-01-04.
- ^ a b Kabir MA, Hussain MA, Ahmad Z (2012). "Candida albicans: A Model Organism for Studying Fungal Pathogens". ISRN Microbiology. 2012: 538694. doi:10.5402/2012/538694. PMC 3671685. PMID 23762753.
- ^ Kadosh D (December 2019). "Regulatory mechanisms controlling morphology and pathogenesis in Candida albicans". Current Opinion in Microbiology. 52: 27–34. doi:10.1016/j.mib.2019.04.005. PMC 6874724. PMID 31129557.
- ^ Basso V, d'Enfert C, Znaidi S, Bachellier-Bassi S (2019). "From Genes to Networks: The Regulatory Circuitry Controlling Candida albicans Morphogenesis". Fungal Physiology and Immunopathogenesis. Current Topics in Microbiology and Immunology. Vol. 422. pp. 61–99. doi:10.1007/82_2018_144. ISBN 978-3-030-30236-8. PMID 30368597.
- ^ Hickman MA, Zeng G, Forche A, Hirakawa MP, Abbey D, Harrison BD, et al. (February 2013). "The 'obligate diploid' Candida albicans forms mating-competent haploids". Nature. 494 (7435): 55–59. Bibcode:2013Natur.494...55H. doi:10.1038/nature11865. PMC 3583542. PMID 23364695.
- ^ a b "Candida albicans SC5314 Genome Snapshot/Overview". www.candidagenome.org. Archived from the original on 16 November 2018. Retrieved 27 March 2018.
- ^ Sevilla MJ, Odds FC (November 1986). "Development of Candida albicans hyphae in different growth media--variations in growth rates, cell dimensions and timing of morphogenetic events". Journal of General Microbiology. 132 (11): 3083–3088. doi:10.1099/00221287-132-11-3083. PMID 3305781.
- ^ Odds FC, Bernaerts R (August 1994). "CHROMagar Candida, a new differential isolation medium for presumptive identification of clinically important Candida species". Journal of Clinical Microbiology. 32 (8): 1923–1929. doi:10.1128/JCM.32.8.1923-1929.1994. PMC 263904. PMID 7989544.
- ^ Simi V. "Origin of the Names of Species of Candida" (PDF). Archived (PDF) from the original on 2015-06-21. Retrieved 2017-05-17.
- ^ McCool L. "The Discovery and Naming of Candida albicans" (PDF). Archived (PDF) from the original on 2018-05-05. Retrieved 2017-05-17.
- ^ a b Roemer T, Jiang B, Davison J, Ketela T, Veillette K, Breton A, et al. (October 2003). "Large-scale essential gene identification in Candida albicans and applications to antifungal drug discovery". Molecular Microbiology. 50 (1): 167–181. doi:10.1046/j.1365-2958.2003.03697.x. PMID 14507372. S2CID 6773779.
- ^ a b "Candida Community News". www.candidagenome.org. Archived from the original on 27 October 2018. Retrieved 27 March 2018.
- ^ "Candida Strains". www.candidagenome.org. Archived from the original on 27 October 2018. Retrieved 27 March 2018.
- ^ Rustchenko-Bulgac EP (October 1991). "Variations of Candida albicans electrophoretic karyotypes". Journal of Bacteriology. 173 (20): 6586–6596. doi:10.1128/jb.173.20.6586-6596.1991. PMC 208996. PMID 1917880.
- ^ Holmes AR, Tsao S, Ong SW, Lamping E, Niimi K, Monk BC, et al. (October 2006). "Heterozygosity and functional allelic variation in the Candida albicans efflux pump genes CDR1 and CDR2". Molecular Microbiology. 62 (1): 170–186. doi:10.1111/j.1365-2958.2006.05357.x. PMID 16942600. S2CID 11838673.
- ^ Jones T, Federspiel NA, Chibana H, Dungan J, Kalman S, Magee BB, et al. (May 2004). "The diploid genome sequence of Candida albicans". Proceedings of the National Academy of Sciences of the United States of America. 101 (19): 7329–7334. Bibcode:2004PNAS..101.7329J. doi:10.1073/pnas.0401648101. PMC 409918. PMID 15123810.
- ^ Ohama T, Suzuki T, Mori M, Osawa S, Ueda T, Watanabe K, Nakase T (August 1993). "Non-universal decoding of the leucine codon CUG in several Candida species". Nucleic Acids Research. 21 (17): 4039–4045. doi:10.1093/nar/21.17.4039. PMC 309997. PMID 8371978.
- ^ Arnaud, MB, Costanzo, MC, Inglis, DO, Skrzypek, MS, Binkley, J, Shah, P, Binkley, G, Miyasato, SR, Sherlock, G. "CGD Help: Non-standard Genetic Codes". Candida Genome Database. Archived from the original on 1 November 2018. Retrieved 30 October 2011.
- ^ Andrzej (Anjay) Elzanowski and Jim Ostell (7 July 2010). "The Alternative Yeast Nuclear Code". The Genetic Codes. Bethesda, Maryland, U.S.A.: National Center for Biotechnology Information (NCBI). Archived from the original on 13 May 2011. Retrieved 30 October 2011.
- ^ Santos MA, Cheesman C, Costa V, Moradas-Ferreira P, Tuite MF (February 1999). "Selective advantages created by codon ambiguity allowed for the evolution of an alternative genetic code in Candida spp". Molecular Microbiology. 31 (3): 937–947. doi:10.1046/j.1365-2958.1999.01233.x. PMID 10048036. S2CID 28572737.
- ^ a b c d Stynen B, Van Dijck P, Tournu H (October 2010). "A CUG codon adapted two-hybrid system for the pathogenic fungus Candida albicans". Nucleic Acids Research. 38 (19): e184. doi:10.1093/nar/gkq725. PMC 2965261. PMID 20719741.
- ^ a b Butler G, Rasmussen MD, Lin MF, Santos MA, Sakthikumar S, Munro CA, et al. (June 2009). "Evolution of pathogenicity and sexual reproduction in eight Candida genomes". Nature. 459 (7247): 657–662. Bibcode:2009Natur.459..657B. doi:10.1038/nature08064. PMC 2834264. PMID 19465905.
- ^ Silva RM, Paredes JA, Moura GR, Manadas B, Lima-Costa T, Rocha R, et al. (October 2007). "Critical roles for a genetic code alteration in the evolution of the genus Candida". The EMBO Journal. 26 (21): 4555–4565. doi:10.1038/sj.emboj.7601876. PMC 2063480. PMID 17932489.
- ^ a b Slutsky B, Staebell M, Anderson J, Risen L, Pfaller M, Soll DR (January 1987). ""White-opaque transition": a second high-frequency switching system in Candida albicans". Journal of Bacteriology. 169 (1): 189–197. doi:10.1128/jb.169.1.189-197.1987. PMC 211752. PMID 3539914.
- ^ a b Slutsky B, Buffo J, Soll DR (November 1985). "High-frequency switching of colony morphology in Candida albicans". Science. 230 (4726): 666–669. Bibcode:1985Sci...230..666S. doi:10.1126/science.3901258. PMID 3901258.
- ^ a b Soll DR (April 1992). "High-frequency switching in Candida albicans". Clinical Microbiology Reviews. 5 (2): 183–203. doi:10.1128/cmr.5.2.183. PMC 358234. PMID 1576587.
- ^ Reiss E, DiSalvo A (2018). "Mycology - Yeasts". In Hunt RC (ed.). Microbiology and Immunology On-line. Archived from the original on 3 January 2021. Retrieved 7 September 2020.
- ^ Foss S (22 July 2013). "Candida albicans". Archived from the original on 18 November 2023. Retrieved 24 October 2017.
- ^ Staniszewska M, Bondaryk M, Siennicka K, Kurzatkowski W (2012). "Ultrastructure of Candida albicans pleomorphic forms: phase-contrast microscopy, scanning and transmission electron microscopy". Polish Journal of Microbiology. 61 (2): 129–135. doi:10.33073/pjm-2012-016. PMID 23163212.
- ^ Si H, Hernday AD, Hirakawa MP, Johnson AD, Bennett RJ (March 2013). "Candida albicans white and opaque cells undergo distinct programs of filamentous growth". PLOS Pathogens. 9 (3): e1003210. doi:10.1371/journal.ppat.1003210. PMC 3591317. PMID 23505370.
- ^ Sudbery PE (August 2011). "Growth of Candida albicans hyphae". Nature Reviews. Microbiology. 9 (10): 737–748. doi:10.1038/nrmicro2636. PMID 21844880. S2CID 205498076. See figure 2 Archived 2018-12-15 at the Wayback Machine.
- ^ Sudbery P, Gow N, Berman J (July 2004). "The distinct morphogenic states of Candida albicans". Trends in Microbiology. 12 (7): 317–324. doi:10.1016/j.tim.2004.05.008. PMID 15223059.
- ^ Jiménez-López C, Lorenz MC (2013). "Fungal immune evasion in a model host-pathogen interaction: Candida albicans versus macrophages". PLOS Pathogens. 9 (11): e1003741. doi:10.1371/journal.ppat.1003741. PMC 3836912. PMID 24278014.
- ^ Berman J, Sudbery PE (December 2002). "Candida Albicans: a molecular revolution built on lessons from budding yeast". Nature Reviews. Genetics. 3 (12): 918–930. doi:10.1038/nrg948. PMID 12459722. S2CID 29341377.
- ^ Shareck J, Belhumeur P (August 2011). "Modulation of morphogenesis in Candida albicans by various small molecules". Eukaryotic Cell. 10 (8): 1004–1012. doi:10.1128/EC.05030-11. PMC 3165445. PMID 21642508.
- ^ Staib P, Morschhäuser J (January 2007). "Chlamydospore formation in Candida albicans and Candida dubliniensis--an enigmatic developmental programme". Mycoses. 50 (1): 1–12. doi:10.1111/j.1439-0507.2006.01308.x. PMID 17302741. S2CID 7387908.
- ^ Sohn K, Urban C, Brunner H, Rupp S (January 2003). "EFG1 is a major regulator of cell wall dynamics in Candida albicans as revealed by DNA microarrays". Molecular Microbiology. 47 (1): 89–102. doi:10.1046/j.1365-2958.2003.03300.x. PMID 12492856. S2CID 23743789.
- ^ Shapiro RS, Robbins N, Cowen LE (June 2011). "Regulatory circuitry governing fungal development, drug resistance, and disease". Microbiology and Molecular Biology Reviews. 75 (2): 213–267. doi:10.1128/MMBR.00045-10. PMC 3122626. PMID 21646428.
- ^ Soll DR (January 2014). "The role of phenotypic switching in the basic biology and pathogenesis of Candida albicans". Journal of Oral Microbiology. 6 (2): 895–9. doi:10.3402/jom.v6.22993. PMC 3895265. PMID 24455104.
- ^ Alby K, J R (November 2009). "To switch or not to switch?: Phenotypic switching is sensitive to multiple inputs in a pathogenic fungus". Communicative & Integrative Biology. 2 (6): 509–511. doi:10.4161/cib.2.6.9487. PMC 2829826. PMID 20195457.
- ^ Vargas K, Wertz PW, Drake D, Morrow B, Soll DR (April 1994). "Differences in adhesion of Candida albicans 3153A cells exhibiting switch phenotypes to buccal epithelium and stratum corneum". Infection and Immunity. 62 (4): 1328–1335. doi:10.1128/IAI.62.4.1328-1335.1994. PMC 186281. PMID 8132340.
- ^ a b c Tao L, Du H, Guan G, Dai Y, Nobile CJ, Liang W, et al. (April 2014). "Discovery of a "white-gray-opaque" tristable phenotypic switching system in candida albicans: roles of non-genetic diversity in host adaptation". PLOS Biology. 12 (4): e1001830. doi:10.1371/journal.pbio.1001830. PMC 3972085. PMID 24691005.
- ^ Pérez-Martín J, Uría JA, Johnson AD (May 1999). "Phenotypic switching in Candida albicans is controlled by a SIR2 gene". The EMBO Journal. 18 (9): 2580–2592. doi:10.1093/emboj/18.9.2580. PMC 1171338. PMID 10228170.
- ^ Dean L, McEntyre J (24 November 1999). "How Candida albicans switches phenotype - and back again". Coffee Break: Tutorials for NCBI Tools. National Center for Biotechnology Information (US). Archived from the original on 8 July 2022. Retrieved 7 January 2020.
- ^ "SIR2 | SGD". www.yeastgenome.org. Archived from the original on 2023-11-18. Retrieved 2020-01-07.
- ^ a b Rikkerink EH, Magee BB, Magee PT (February 1988). "Opaque-white phenotype transition: a programmed morphological transition in Candida albicans". Journal of Bacteriology. 170 (2): 895–899. doi:10.1128/jb.170.2.895-899.1988. PMC 210739. PMID 2828333.
- ^ Lohse MB, Johnson AD (December 2009). "White-opaque switching in Candida albicans". Current Opinion in Microbiology. 12 (6): 650–654. doi:10.1016/j.mib.2009.09.010. PMC 2812476. PMID 19853498.
- ^ Hnisz D, Tscherner M, Kuchler K (2011). "Morphological and Molecular Genetic Analysis of Epigenetic Switching of the Human Fungal Pathogen Candida albicans". Yeast Genetic Networks. Methods in Molecular Biology. Vol. 734. pp. 303–315. doi:10.1007/978-1-61779-086-7_15. ISBN 978-1-61779-085-0. PMID 21468996.
- ^ Morschhäuser J (August 2010). "Regulation of white-opaque switching in Candida albicans". Medical Microbiology and Immunology. 199 (3): 165–172. doi:10.1007/s00430-010-0147-0. PMID 20390300. S2CID 8770123.
- ^ a b SLiang SH, Anderson MZ, Hirakawa MP, Wang JM, Frazer C, Alaalm LM, Thomson GJ, Ene IV, Bennett RJ (March 2019). "Hemizygosity enables a mutational transition governing fungal virulence and commensalism". Cell Host Microbe. 25 (3): 418–431.e6. doi:10.1016/j.chom.2019.01.005. PMC 6624852. PMID 30824263.
- ^ Sonneborn A, Tebarth B, Ernst JF (September 1999). "Control of white-opaque phenotypic switching in Candida albicans by the Efg1p morphogenetic regulator". Infection and Immunity. 67 (9): 4655–4660. doi:10.1128/IAI.67.9.4655-4660.1999. PMC 96790. PMID 10456912.
- ^ Srikantha T, Tsai LK, Daniels K, Soll DR (March 2000). "EFG1 null mutants of Candida albicans switch but cannot express the complete phenotype of white-phase budding cells". Journal of Bacteriology. 182 (6): 1580–1591. doi:10.1128/JB.182.6.1580-1591.2000. PMC 94455. PMID 10692363.
- ^ a b Guan G, Tao L, Yue H, Liang W, Gong J, Bing J, et al. (March 2019). "Environment-induced same-sex mating in the yeast Candida albicans through the Hsf1-Hsp90 pathway". PLOS Biology. 17 (3): e2006966. doi:10.1371/journal.pbio.2006966. PMC 6415874. PMID 30865631.
- ^ Pande K, Chen C, Noble SM (September 2013). "Passage through the mammalian gut triggers a phenotypic switch that promotes Candida albicans commensalism". Nature Genetics. 45 (9): 1088–1091. doi:10.1038/ng.2710. PMC 3758371. PMID 23892606.
- ^ Noble SM, Gianetti BA, Witchley JN (February 2017). "Candida albicans cell-type switching and functional plasticity in the mammalian host". Nature Reviews. Microbiology. 15 (2): 96–108. doi:10.1038/nrmicro.2016.157. PMC 5957277. PMID 27867199.
- ^ a b Brosnahan M (July 22, 2013). "Candida Albicans". MicrobeWiki. Kenyon College. Archived from the original on November 18, 2023. Retrieved October 24, 2016.
- ^ Sydnor ER, Perl TM (January 2011). "Hospital epidemiology and infection control in acute-care settings". Clinical Microbiology Reviews. 24 (1): 141–173. doi:10.1128/CMR.00027-10. PMC 3021207. PMID 21233510.
- ^ Sardi JC, Scorzoni L, Bernardi T, Fusco-Almeida AM, Mendes Giannini MJ (January 2013). "Candida species: current epidemiology, pathogenicity, biofilm formation, natural antifungal products and new therapeutic options". Journal of Medical Microbiology. 62 (Pt 1): 10–24. doi:10.1099/jmm.0.045054-0. PMID 23180477.
- ^ Tortora, Funke, Case. Microbiology, An Introduction 10th Edition. Pearson Benjamin Cummings. 2004, 2007, 2010.
- ^ Vazquez J (2016-04-16). "Epidemiology, Management, and Prevention of Invasive Candidiasis". Medscape.org. Medscape. Archived from the original on 2014-03-08. Retrieved 2016-04-16.
- ^ Zadik Y, Burnstein S, Derazne E, Sandler V, Ianculovici C, Halperin T (March 2010). "Colonization of Candida: prevalence among tongue-pierced and non-pierced immunocompetent adults". Oral Diseases. 16 (2): 172–175. doi:10.1111/j.1601-0825.2009.01618.x. PMID 19732353.
- ^ Yitschaky O, Katorza A, Zini A, Yitschaky M, Zadik Y (January 2016). "Acrylic orthodontic retainer is not a risk factor for focal Candida colonization in young healthy patients: a pilot study". Oral Surgery, Oral Medicine, Oral Pathology and Oral Radiology. 121 (1): 39–42. doi:10.1016/j.oooo.2015.10.001. PMID 26679358.
- ^ Ryan KJ, Ray CG, eds. (2004). Sherris Medical Microbiology (4th ed.). McGraw Hill. ISBN 978-0-8385-8529-0.
- ^ Tortora GJ (2010). Microbiology: an Introduction. San Francisco, CA: Pearson Benjamin Cummings. pp. 759.
- ^ Mukherjee PK, Sendid B, Hoarau G, Colombel JF, Poulain D, Ghannoum MA (February 2015). "Mycobiota in gastrointestinal diseases". Nature Reviews. Gastroenterology & Hepatology. 12 (2): 77–87. doi:10.1038/nrgastro.2014.188. PMID 25385227. S2CID 5370536.
- ^ Peters BM, Jabra-Rizk MA, Scheper MA, Leid JG, Costerton JW, Shirtliff ME (August 2010). "Microbial interactions and differential protein expression in Staphylococcus aureus -Candida albicans dual-species biofilms". FEMS Immunology and Medical Microbiology. 59 (3): 493–503. doi:10.1111/j.1574-695X.2010.00710.x. PMC 2936118. PMID 20608978.
- ^ Saygin D, Tabib T, Bittar HE, Valenzi E, Sembrat J, Chan SY, et al. (2013). "Transcriptional profiling of lung cell populations in idiopathic pulmonary arterial hypertension". Pulmonary Circulation. 10 (1): 30–39. doi:10.1893/0005-3155-84.1.30. PMC 7052475. PMID 32166015. S2CID 96930404.
- ^ Zago CE, Silva S, Sanitá PV, Barbugli PA, Dias CM, Lordello VB, Vergani CE (2015). "Dynamics of biofilm formation and the interaction between Candida albicans and methicillin-susceptible (MSSA) and -resistant Staphylococcus aureus (MRSA)". PLOS ONE. 10 (4): e0123206. Bibcode:2015PLoSO..1023206Z. doi:10.1371/journal.pone.0123206. PMC 4395328. PMID 25875834.
- ^ Tortora GJ (2010). Mibrobiology:an Introduction. San Francisco, CA: Pearson Benjamin Cummings. p. 758.
- ^ Weinberger M, Leibovici L, Perez S, Samra Z, Ostfeld I, Levi I, et al. (October 2005). "Characteristics of candidaemia with Candida-albicans compared with non-albicans Candida species and predictors of mortality". The Journal of Hospital Infection. 61 (2): 146–154. doi:10.1016/j.jhin.2005.02.009. PMID 16009456.
- ^ Yapar N (2016-04-16). "Epidemiology and risk factors for invasive candidiasis". Therapeutics and Clinical Risk Management. 10: 95–105. doi:10.2147/TCRM.S40160. PMC 3928396. PMID 24611015.
- ^ "Fungal Diseases." Centers for Disease Control and Prevention, Centers for Disease Control and Prevention, 12 June 2015, www.cdc.gov/fungal/diseases/candidiasis/invasive/diagnosis.html.
- ^ "Yeasts". www.microbiologybook.org. Archived from the original on 14 March 2018. Retrieved 27 March 2018.
- ^ Poulain D, Sendid B, Standaert-Vitse A, Fradin C, Jouault T, Jawhara S, Colombel JF (2009). "Yeasts: neglected pathogens". Digestive Diseases. 27 (Suppl 1): 104–110. doi:10.1159/000268129. PMID 20203505. S2CID 9014160.
- ^ Jawhara S, Poulain D (December 2007). "Saccharomyces boulardii decreases inflammation and intestinal colonization by Candida albicans in a mouse model of chemically-induced colitis". Medical Mycology. 45 (8): 691–700. doi:10.1080/13693780701523013. PMID 17885943.
- ^ Jawhara S, Thuru X, Standaert-Vitse A, Jouault T, Mordon S, Sendid B, et al. (April 2008). "Colonization of mice by Candida albicans is promoted by chemically induced colitis and augments inflammatory responses through galectin-3". The Journal of Infectious Diseases. 197 (7): 972–980. doi:10.1086/528990. PMID 18419533.
- ^ Eguiguren L, Lee BR, Newland JG, Kronman MP, Hersh AL, Gerber JS, et al. (2022). "Characteristics of antifungal utilization for hospitalized children in the United States". Antimicrob Steward Healthc Epidemiol. 2 (1): e190. doi:10.1017/ash.2022.338. PMC 9726632. PMID 36505943.
{{cite journal}}: CS1 maint: multiple names: authors list (link) - ^ a b Chapter IV. Germ Tube Test in YEAST IDENTIFICATION Archived 2011-09-27 at the Wayback Machine document at doctorfungus.org. Retrieved July 2011
- ^ a b Sellam A, Whiteway M (2016). "Recent advances on Candida albicans biology and virulence". F1000Research. 5: 2582. doi:10.12688/f1000research.9617.1. PMC 5089126. PMID 27853524.
- ^ "Stop neglecting fungi". Nature Microbiology. 2 (8) 17120. July 2017. doi:10.1038/nmicrobiol.2017.120. PMID 28741610.
- ^ Rambach G, Oberhauser H, Speth C, Lass-Flörl C (November 2011). "Susceptibility of Candida species and various moulds to antimycotic drugs: use of epidemiological cutoff values according to EUCAST and CLSI in an 8-year survey". Medical Mycology. 49 (8): 856–863. doi:10.3109/13693786.2011.583943. PMID 21619497.
- ^ Tortora GJ, Funke BR, Case CL (2002). Microbiology an Introduction (10th ed.). San Francisco, CA.: Pearson Benjamin Cummings. pp. 759.
- ^ "Antifungal Resistance – Fungal Diseases – CDC". www.cdc.gov. 26 June 2017. Archived from the original on 19 May 2017. Retrieved 27 March 2018.
- ^ "Stop neglecting fungi". Editorial. Nature Microbiology. 2 (8) 17120. July 2017. doi:10.1038/nmicrobiol.2017.120. PMID 28741610.
- ^ "Fungus vs. Fungus: Newly Identified Yeast Might Prevent Life-Threatening Fungal Infections | Weizmann USA". American Committee for the Weizmann Institute of Science. 2024-03-18. Retrieved 2025-08-08.
- ^ Uppuluri P, Khan A, Edwards JE (2017). "Current Trends in Candidiasis". In Prasad R (ed.). Candida albicans: Cellular and Molecular Biology. Switzerland: Springer International Publishing AG. p. 6. ISBN 978-3-319-50408-7.
- ^ Wilson LS, Reyes CM, Stolpman M, Speckman J, Allen K, Beney J (2002). "The direct cost and incidence of systemic fungal infections". Value in Health. 5 (1): 26–34. doi:10.1046/j.1524-4733.2002.51108.x. PMID 11873380.
- ^ Rentz AM, Halpern MT, Bowden R (October 1998). "The impact of candidemia on length of hospital stay, outcome, and overall cost of illness". Clinical Infectious Diseases. 27 (4): 781–788. doi:10.1086/514955. PMID 9798034.
- ^ Ding X, Kambara H, Guo R, Kanneganti A, Acosta-Zaldívar M, Li J, Liu F, Bei T, Qi W, Xie X, Han W, Liu N, Zhang C, Zhang X, Yu H (2021-11-18). "Inflammasome-mediated GSDMD activation facilitates escape of Candida albicans from macrophages". Nature Communications. 12 (1): 6699. Bibcode:2021NatCo..12.6699D. doi:10.1038/s41467-021-27034-9. ISSN 2041-1723. PMC 8602704. PMID 34795266.
- ^ McCall AD, Pathirana RU, Prabhakar A, Cullen PJ, Edgerton M (23 August 2019). "Candida albicans biofilm development is governed by cooperative attachment and adhesion maintenance proteins". npj Biofilms and Microbiomes. 5 (1) 21. doi:10.1038/s41522-019-0094-5. PMC 6707306. PMID 31452924.
- ^ Chandra J, Kuhn DM, Mukherjee PK, Hoyer LL, McCormick T, Ghannoum MA (September 2001). "Biofilm formation by the fungal pathogen Candida albicans: development, architecture, and drug resistance". Journal of Bacteriology. 183 (18): 5385–5394. doi:10.1128/jb.183.18.5385-5394.2001. PMC 95423. PMID 11514524.
- ^ Gulati M, Nobile CJ (May 2016). "Candida albicans biofilms: development, regulation, and molecular mechanisms". Microbes and Infection. 18 (5): 310–321. doi:10.1016/j.micinf.2016.01.002. PMC 4860025. PMID 26806384.
- ^ Finkel JS, Mitchell AP (February 2011). "Genetic control of Candida albicans biofilm development". Nature Reviews. Microbiology. 9 (2): 109–118. doi:10.1038/nrmicro2475. PMC 3891587. PMID 21189476.
- ^ Claus J, Chavarría-Krauser A (2012-06-08). "Modeling regulation of zinc uptake via ZIP transporters in yeast and plant roots". PLOS ONE. 7 (6): e37193. arXiv:1202.4335. Bibcode:2012PLoSO...737193C. doi:10.1371/journal.pone.0037193. PMC 3371047. PMID 22715365.
- ^ Azadmanesh J, Gowen AM, Creger PE, Schafer ND, Blankenship JR (November 2017). "Filamentation Involves Two Overlapping, but Distinct, Programs of Filamentation in the Pathogenic Fungus Candida albicans". G3. 7 (11): 3797–3808. doi:10.1534/g3.117.300224. PMC 5677161. PMID 28951491.
- ^ Lorenz MC, Bender JA, Fink GR (October 2004). "Transcriptional response of Candida albicans upon internalization by macrophages". Eukaryotic Cell. 3 (5): 1076–1087. doi:10.1128/EC.3.5.1076-1087.2004. PMC 522606. PMID 15470236.
- ^ Westman J, Moran G, Mogavero S, Hube B, Grinstein S (September 2018). "Candida albicans Hyphal Expansion Causes Phagosomal Membrane Damage and Luminal Alkalinization". mBio. 9 (5): e01226–18. doi:10.1128/mBio.01226-18. PMC 6134096. PMID 30206168.
- ^ Staab JF, Bradway SD, Fidel PL, Sundstrom P (March 1999). "Adhesive and mammalian transglutaminase substrate properties of Candida albicans Hwp1". Science. 283 (5407): 1535–1538. Bibcode:1999Sci...283.1535S. doi:10.1126/science.283.5407.1535. PMID 10066176.
- ^ Ariyachet C, Solis NV, Liu Y, Prasadarao NV, Filler SG, McBride AE (April 2013). "SR-like RNA-binding protein Slr1 affects Candida albicans filamentation and virulence". Infection and Immunity. 81 (4): 1267–1276. doi:10.1128/IAI.00864-12. PMC 3639594. PMID 23381995.
- ^ Wilson D, Naglik JR, Hube B (October 2016). "The Missing Link between Candida albicans Hyphal Morphogenesis and Host Cell Damage". PLOS Pathogens. 12 (10): e1005867. doi:10.1371/journal.ppat.1005867. PMC 5072684. PMID 27764260.
- ^ Roselletti E, Pericolini E, Nore A, Takacs P, Kozma B, Sala A, De Seta F, Comar M, Usher J, Brown GD, Wilson D (2023-12-06). "Zinc prevents vaginal candidiasis by inhibiting expression of an inflammatory fungal protein". Science Translational Medicine. 15 (725): eadi3363. doi:10.1126/scitranslmed.adi3363. hdl:10871/134775. ISSN 1946-6234. PMC 7616067. PMID 38055800.
- ^ Shen J, Guo W, Köhler JR (February 2005). "CaNAT1, a heterologous dominant selectable marker for transformation of Candida albicans and other pathogenic Candida species". Infection and Immunity. 73 (2): 1239–1242. doi:10.1128/IAI.73.2.1239-1242.2005. PMC 547112. PMID 15664973.
- ^ Cheng S, Nguyen MH, Zhang Z, Jia H, Handfield M, Clancy CJ (October 2003). "Evaluation of the roles of four Candida albicans genes in virulence by using gene disruption strains that express URA3 from the native locus". Infection and Immunity. 71 (10): 6101–6103. doi:10.1128/IAI.71.10.6101-6103.2003. PMC 201070. PMID 14500538.
- ^ Noble SM, Johnson AD (February 2005). "Strains and strategies for large-scale gene deletion studies of the diploid human fungal pathogen Candida albicans". Eukaryotic Cell. 4 (2): 298–309. doi:10.1128/EC.4.2.298-309.2005. PMC 549318. PMID 15701792.
- ^ van het Hoog M, Rast TJ, Martchenko M, Grindle S, Dignard D, Hogues H, et al. (2007). "Assembly of the Candida albicans genome into sixteen supercontigs aligned on the eight chromosomes". Genome Biology. 8 (4) R52. doi:10.1186/gb-2007-8-4-r52. PMC 1896002. PMID 17419877.
- ^ Cabral V, Chauevl M, Firon A, Legrand M, Nesseir A, Bachellier-Bassi S, et al. (2012). "Modular Gene Over-expression Strategies for Candida albicans". In Brand AC, MacCallum DM (eds.). Host-Fungus Interactions. Methods in Molecular Biology. Vol. 845. pp. 227–244. doi:10.1007/978-1-61779-539-8_15. ISBN 978-1-61779-538-1. PMID 22328378.
- ^ Chauvel M, Nesseir A, Cabral V, Znaidi S, Goyard S, Bachellier-Bassi S, et al. (2012). "A versatile overexpression strategy in the pathogenic yeast Candida albicans: identification of regulators of morphogenesis and fitness". PLOS ONE. 7 (9): e45912. Bibcode:2012PLoSO...745912C. doi:10.1371/journal.pone.0045912. PMC 3457969. PMID 23049891.
- ^ a b Walker LA, Maccallum DM, Bertram G, Gow NA, Odds FC, Brown AJ (February 2009). "Genome-wide analysis of Candida albicans gene expression patterns during infection of the mammalian kidney". Fungal Genetics and Biology. 46 (2): 210–219. doi:10.1016/j.fgb.2008.10.012. PMC 2698078. PMID 19032986.
- ^ Legrand M, Bachellier-Bassi S, Lee KK, Chaudhari Y, Tournu H, Arbogast L, et al. (August 2018). "Generating genomic platforms to study Candida albicans pathogenesis". Nucleic Acids Research. 46 (14): 6935–6949. doi:10.1093/nar/gky594. PMC 6101633. PMID 29982705.
- ^ Schoeters F, Munro CA, d'Enfert C, Van Dijck P (August 2018). "A High-Throughput Candida albicans Two-Hybrid System". mSphere. 3 (4). doi:10.1128/mSphere.00391-18. PMC 6106057. PMID 30135223.
- ^ a b Schoeters F, Van Dijck P (2019). "Protein-Protein Interactions in Candida albicans". Frontiers in Microbiology. 10: 1792. doi:10.3389/fmicb.2019.01792. PMC 6693483. PMID 31440220.
- ^ Tyers M. "BioGRID - Database of Protein, Chemical, and Genetic Interactions". thebiogrid.org. Archived from the original on 2017-09-11. Retrieved 2018-08-25.
- ^ Subotić A, Swinnen E, Demuyser L, De Keersmaecker H, Mizuno H, Tournu H, Van Dijck P (October 2017). "A Bimolecular Fluorescence Complementation Tool for Identification of Protein-Protein Interactions in Candida albicans". G3. 7 (10): 3509–3520. doi:10.1534/g3.117.300149. PMC 5633398. PMID 28860184.
- ^ Mamouei Z, Zeng G, Wang YM, Wang Y (December 2017). "Candida albicans possess a highly versatile and dynamic high-affinity iron transport system important for its commensal-pathogenic lifestyle". Molecular Microbiology. 106 (6): 986–998. doi:10.1111/mmi.13864. PMID 29030877.
- ^ Mochon AB, Jin Y, Kayala MA, Wingard JR, Clancy CJ, Nguyen MH, et al. (March 2010). "Serological profiling of a Candida albicans protein microarray reveals permanent host-pathogen interplay and stage-specific responses during candidemia". PLOS Pathogens. 6 (3): e1000827. doi:10.1371/journal.ppat.1000827. PMC 2845659. PMID 20361054.
- ^ Dean N, Ng H (April 2018). "Method for CRISPR/Cas9 Mutagenesis in Candida albicans". Bio-Protocol. 8 (8): e2814. doi:10.21769/BioProtoc.2814. PMC 8275232. PMID 34286028. S2CID 90620202.
- ^ Vyas VK, Barrasa MI, Fink GR (2015). "A Candida albicans CRISPR system permits genetic engineering of essential genes and gene families". Science Advances. 1 (3): e1500248. Bibcode:2015SciA....1E0248V. doi:10.1126/sciadv.1500248. PMC 4428347. PMID 25977940.
- ^ Min K, Ichikawa Y, Woolford CA, Mitchell AP (2016). "Candida albicans Gene Deletion with a Transient CRISPR-Cas9 System". mSphere. 1 (3). doi:10.1128/mSphere.00130-16. PMC 4911798. PMID 27340698.
- ^ Saygin D, Tabib T, Bittar HE, Valenzi E, Sembrat J, Chan SY, et al. (2013). "Transcriptional profiling of lung cell populations in idiopathic pulmonary arterial hypertension". Pulmonary Circulation. 10 (1): 111–114. Bibcode:2013ITNan..12..111D. doi:10.1109/TNANO.2013.2239308. PMC 7052475. PMID 32166015. S2CID 26949825.
Further reading
- Odds FC (1988). Candida and candidosis (2nd ed.). Baillière Tindall. ISBN 978-0702012655.
- Waldman A, Gilhar A, Duek L, Berdicevsky I (May 2001). "Incidence of Candida in psoriasis--a study on the fungal flora of psoriatic patients". Mycoses. 44 (3–4): 77–81. doi:10.1046/j.1439-0507.2001.00608.x. PMID 11413927. S2CID 36201859.
- Zordan RE, Miller MG, Galgoczy DJ, Tuch BB, Johnson AD (October 2007). "Interlocking transcriptional feedback loops control white-opaque switching in Candida albicans". PLOS Biology. 5 (10): e256. doi:10.1371/journal.pbio.0050256. PMC 1976629. PMID 17880264.
- Rossignol T, Lechat P, Cuomo C, Zeng Q, Moszer I, d'Enfert C (January 2008). "CandidaDB: a multi-genome database for Candida species and related Saccharomycotina". Nucleic Acids Research. 36 (Database issue): D557 – D561. doi:10.1093/nar/gkm1010. PMC 2238939. PMID 18039716.
- "How Candida albicans switches phenotype – and back again: the SIR2 silencing gene has a say in Candida's colony type". NCBI Coffeebreak. 1999-11-24. Archived from the original on November 13, 2012. Retrieved 2008-11-02.